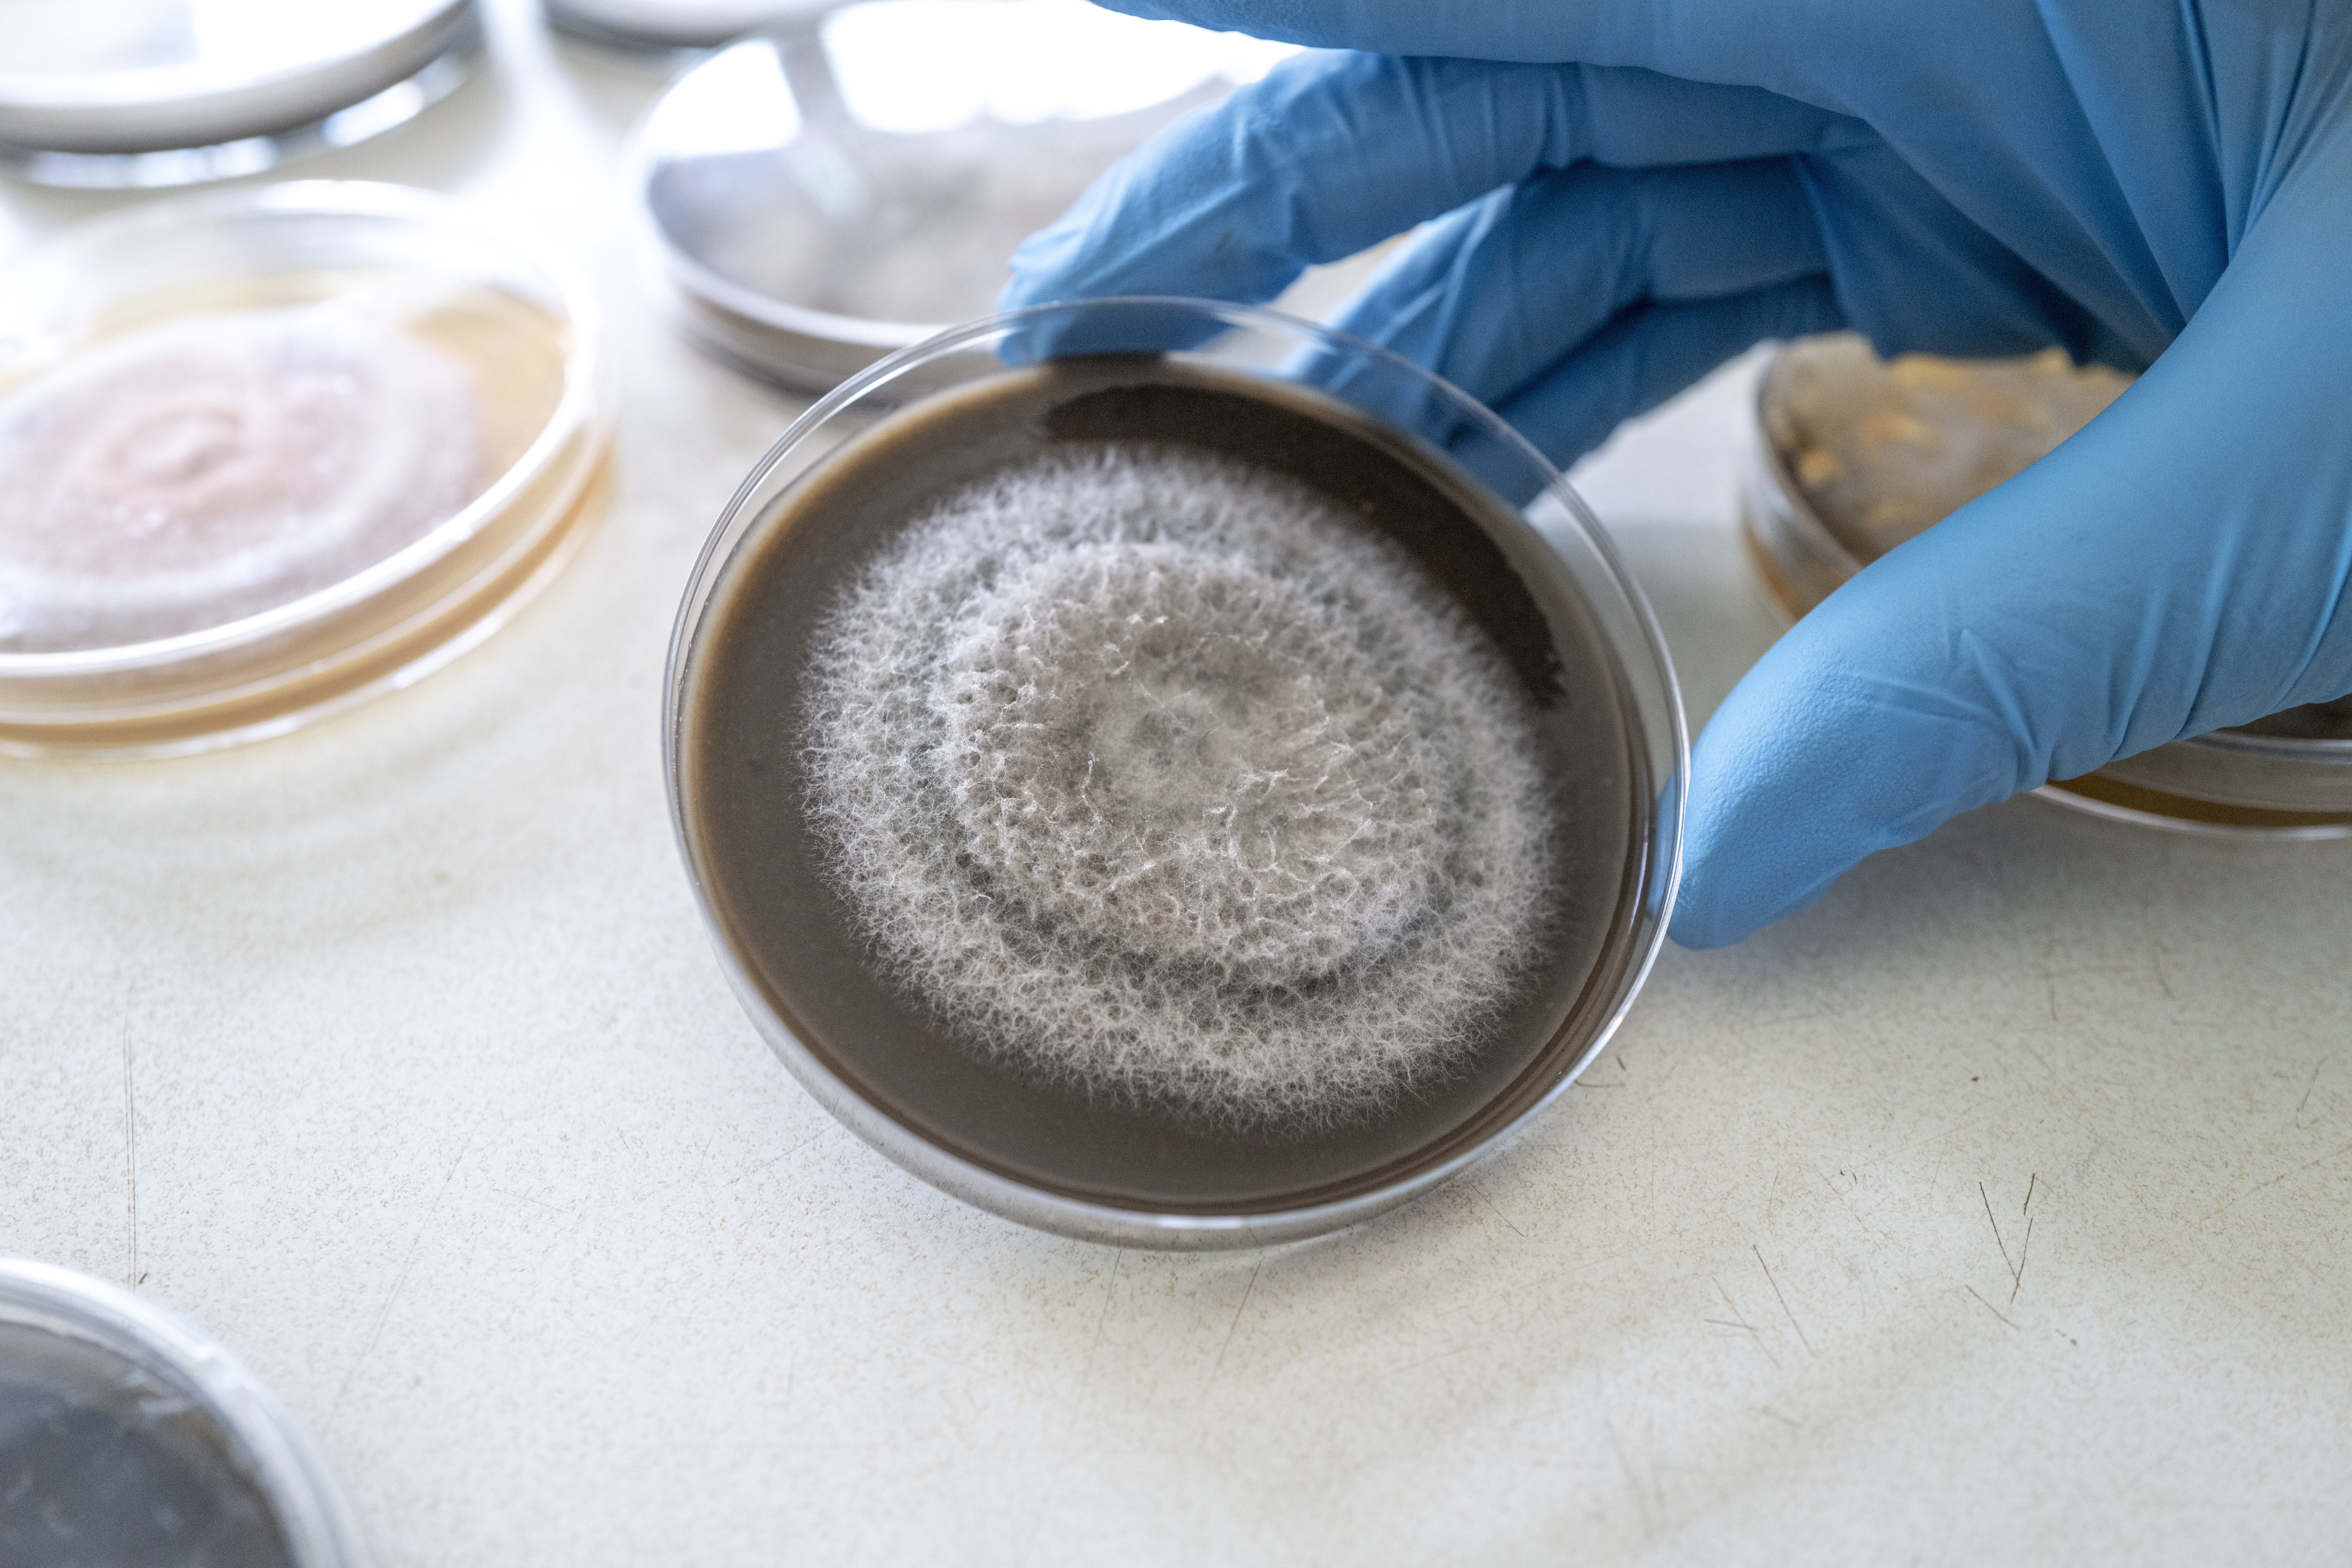

Revolutionizing Waste Management
Transforming faecal sludge into sustainable materials for a cleaner, greener future.By generating value from sustainable recycling of faecal sludge, we are creating the incentive for people to responsibly dispose of their waste. We’ve also created an affordable alternative to cotton and leather imports in the textile industry.
Explore More
Award Winning Laboratory
Ghanaian environmental technologist Abubakari Zarouk Imoro led the creation of Myco-Substitutes in response to the health risks of informal toilets and dumping of faecal sludge.
Explore More